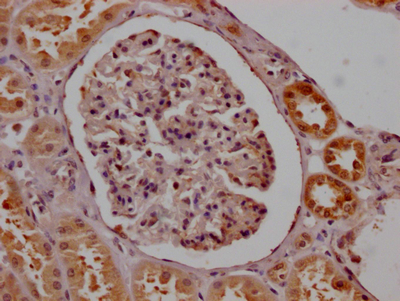
smn1抗體

SMN1基因蛋白過表達質粒構建實驗流程
日期:2023-06-14 13:46:05
一、SMN1基因簡介
脊髓性肌萎縮癥(spinal muscular atrophy,SMA)是一種常見的肌肉萎縮疾病,主要由于SMN1 (survival of motor neuron 1)基因的表達缺陷引起。SMN1基因編碼一個名為survival of motor neuron (SMN)的蛋白,它是一個與細胞核中的前體RNA加工密切相關的蛋白。
SMN蛋白含有一個高度保守的復合物,稱為SMN復合物(SMN complex)。SMN復合物在RNA剪接和轉錄調控中發揮重要作用,并且在神經元運輸過程中也扮演重要角色。SMN1基因突變或缺失導致SMN蛋白量大幅降低,從而導致SMA的發生。
二、SMN1基因蛋白過表達質粒構建
1、實驗設計
通過構建含有SMN1基因的過表達質粒,將其轉染到目標細胞中,實現SMN1抗體蛋白的過量表達。具體實驗設計如下:
(1)采用PCR技術從人類基因組DNA中擴增出SMN1全長序列。
(2)構建SMN1基因的克隆體,插入到適合于目標細胞中表達的質粒載體中。為了方便檢測和分選,可以將SMN1基因與熒光蛋白等標記基因連成一體。
(3)將質粒DNA經過限制性內切酶切割和PCR檢測后,純化出大量的目的質粒。
(4)將純化得到的質粒DNA進行轉染操作,轉移到目標細胞內。
(5)檢測并驗證SMN1蛋白過表達的效果,可以通過Western blot、免疫熒光等方式進行驗證。
2、實驗步驟
(1)擴增SMN1基因全長序列
使用人類基因組DNA作模板,設計引物擴增SMN1基因全長序列。選擇引物時建議能夠擴增出完整的SMN1序列,并且在5’端和3’端加入適當的限制性末端序列方便后續克隆處理。PCR反應方案如下:
| 成分 | 體積/重量 |
| TAE buffer | 10 ul |
| dNTPs (10 mM) | 1 ul |
| Forward primer (10 uM) | 0.5 ul |
| Reverse primer (10 uM) | 0.5 ul |
| Template DNA | 50 ng |
| Taq polymerase (5u/ul) | 0.25 ul |
| ddH2O | 100 ul |
PCR條件如下:
| 步驟 | 溫度 | 時間 |
| 初始變性 | 94°C | 5 min |
|
循環擴增
|
94°C | 30 s |
| 56°C | 30 s | |
| 72°C | 1 min/kbp | |
| 最終延伸 | 72°C | 10 min |
| 保持 | 4°C | ∞ |
(2)構建SMN1基因的克隆體并插入質粒載體中
將擴增出的SMN1基因與合適的質粒載體進行雙酶切,并進行連接處理,得到含有SMN1全長序列的表達質粒。為了方便轉染和檢測,可以選擇帶有熒光標記的質粒載體(例如pEGFP-C1)。實驗操作步驟如下:
a. 雙酶切
將SMN1 PCR產物和質粒載體使用限制性內切酶進行雙酶切,以便插入SMN1 DNA序列,其中使用的RE如下:
SMN1:EcoRI和BamHI
質粒載體:EcoRI和BamHI
b. 連接
將SMN1PCR產物和質粒載體使用T4 DNA ligase聯接,形成含有SMN1基因的過表達質粒。
c. 轉染
將得到的質粒DNA進行轉染操作,轉移到目標細胞中。
(3)檢測SMN1蛋白的過表達效果
通過Western blot、免疫熒光等方式來檢測SMN1蛋白的過表達效果。
a. Western blot
取適量的細胞,進行SDS-PAGE和電轉印,然后進行Western blot分析。使用SMN1抗體和熒光二抗探測SMN1蛋白的表達程度。
b. 免疫熒光
選擇合適的抗SMN1抗體和熒光二抗,利用熒光顯微鏡觀察表達SMN1的細胞。
三、實驗注意事項
PCR反應條件需要根據引物設計和DNA模板質量進行優化,以獲得高效率和特異性擴增產物。
選取合適的質粒載體便于表達和檢測,同時確保質粒對目標細胞有較高的轉染效率。
實驗前充分準備好瓶蓋、移液器、孵育箱等操作工具,并嚴格遵守無菌操作。
轉染處理時,要注意選取合適的轉染試劑和轉染條件,避免不必要的細胞毒性。
在實驗過程中要注意安全,避免接觸實驗物質及其溶液或制品,避免刺傷或感染。
上一篇: wb蛋白實驗二抗的原理
下一篇: NINJ1誘導蛋白表達的載體是什么?












